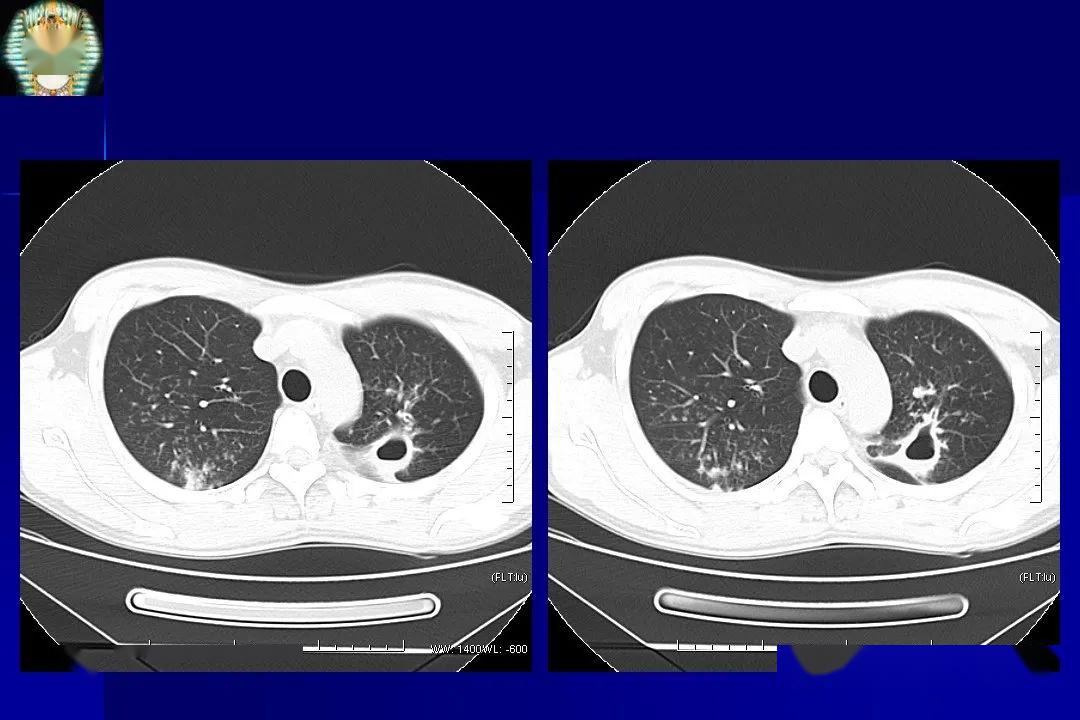
肺结核的影像学诊断_文库

影像诊断学

医学影像诊断学(第3版)——pdf
图片尺寸1536x2048
男,60岁,无明显诱因出现发热 - 影像医学和核医学讨论版 -丁香园论坛
图片尺寸879x992
影像医学和核医学讨论版 -丁香园论坛
图片尺寸1201x704
《医学影像诊断学》
图片尺寸1578x3108
(正版现货) 口腔颌面医学影像诊断学(第5版)(附光盘) 马绪臣
图片尺寸360x500
影像诊断学3中枢ppt
图片尺寸1080x810
影像诊断学
图片尺寸270x383
影像诊断学(第2版)【正版图书】
图片尺寸600x839
急诊影像诊断学
图片尺寸4677x3000
医学影像诊断学(第2版)无光盘
图片尺寸1200x1600
经典胸腔积液的影像学表现
图片尺寸640x480
实用影像诊断学
图片尺寸800x1118
医学影像诊断学精要
图片尺寸2520x3740
医学影像诊断学
图片尺寸270x373
医学影像诊断学(供医学影像技术专业用全国高等学校教材)
图片尺寸547x800
多发性硬化影像学诊断简版
图片尺寸960x720
医学影像诊断学第2版
图片尺寸1200x1600
新型冠状病毒肺炎影像学诊断浅析
图片尺寸1080x608
医学影像学专业课程:包括医学影像物理学,医学影像诊断学,医学影像
图片尺寸1919x1280
肺结核的影像学诊断_文库
图片尺寸1080x720